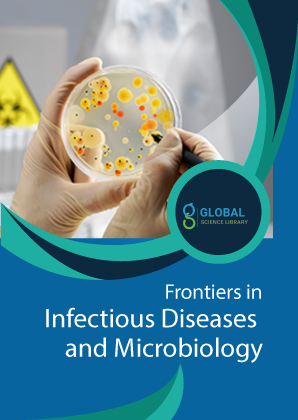

Frontiers in Infectious diseases and Microbiology
Frontiers in Infectious diseases and Microbiology
The topics include but not limited to microbiology, immune responses, vaccine design and development against various pathogenic microorganisms, and the antibiotic resistance etc.
Frontiers in Infectious diseases and Microbiology follows a rapid review process and welcomes direct submission of articles from global authors. Please send your articles at submissions@globalsciencelibrary.com
ISSN: 2771-1838
Editor In chief
Will be updated soon
Editorial Board
Professor Emeritus (Micribiomics)
University of Hong Kong
Hong Kong
Full Distinguished Professor and Academic Tenure of Chemistry
Enrico Fermi Distinguished Chair in Molecular Spectroscopy
Head of Cancer Research Institute (CRI)
Director of the BioSpectroscopy Core Research Laboratory, CSU
USA
Associate Professor
Department of Clinical Pharmacy and Outcomes Sciences
University of South Carolina College of Pharmacy
USA
Professor
Faculty of Chemistry
"Alexandru Ioan Cuza" University of Iasi
Romania
Associate Professor
Faculty of Chemistry
"Alexandru Ioan Cuza" University of Iasi
Romania
Department of General Surgery
Beijing Shijitan Hospital
Peking University Ninth School of Clinical Medicine
China
Department of Microbiology & Immunology
School of Medicine
Georgetown University
USA
Chef d'Unité de Biologie et Recherches Médicales
Département des Sciences du Vivant
Centre National de l'Energie, des Scienceset Techniques nucléaires (CNESTEN)
Morocco
Department of Hematology
AOU Citta' della Salute e della Scienza
Italy
Division Head, Transplant Immunology
Lawson Health Research Institute-Scientist
Assistant Professor
Department of Pathology and Laboratory Medicine
Schulich School of Medicine
London Health Sciences Centre
Canada
In Press
Will be updated soon
Current Issues
Volume: 2 Issue: 2Archive
Publication Charges
Will be updated soon